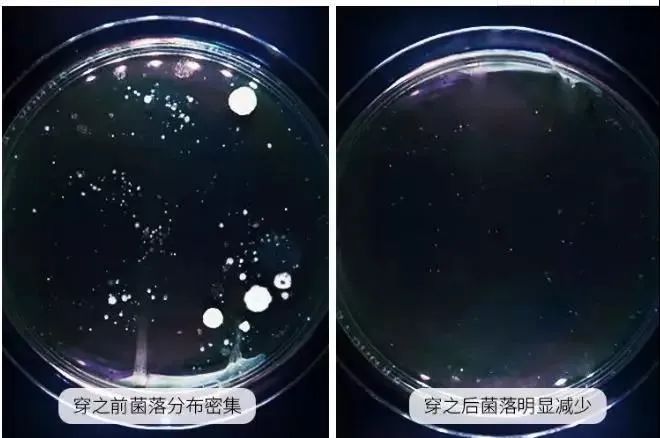

最近朋友发现下体瘙痒难受,还有一股腥臭味,到医院看才知道得了霉菌性yin道炎。

医生说,这种病大多是不良的生活习惯所致!
如内裤不常换,穿不透气、甲醛超标的劣质内裤……

我心里“咯噔”了一下,作为一个颜值党,我选内裤都是看款式花色,穿上贼不舒服。

甚至为了妻情侣间的“小情趣”,挑选蕾丝、化纤/涤纶等不透气的材质,一天下来下面湿漉漉的,特别容易滋生病菌。

而且女性私处是“半开”的,病菌轻而易举就爬进内壁!
特别是最近回南天,内裤更不爱干!
一旦细菌入侵,私处就会瘙痒难忍、排出各种“豆腐渣”、“黄褐色”的白带,还散发出让难以忍受的腥臭味。

就算到医院花大价钱冲洗塞药+经过漫长痛苦的恢复期,依旧会复发……

所以姐妹们,选内裤一定要把舒服放在第一位,好看只是加分项!
说到挑内裤,妇科医生们强烈推荐纯棉内裤
你看婴儿衣服是纯棉,卫生巾也是纯棉,纯棉几乎和安全画上了等号

作为内裤大户的我,今天跟大家分享这款集舒适、颜值于一体的内裤界天花板——7A原棉高腰内裤

第一眼我就知道肯定会有很多姐妹看中它!
既有我爱的大妈内裤舒适感,又有日系少女感的颜值,这谁忍得了!

尤其是裤身精选7A孕婴级别的新疆原棉,孕妇哺乳期都能穿,舒服得要命!

为了验证它的真材实料,我们直接烧它:
左边原棉内裤燃烧殆尽
右边其他混纺面料燃烧不完全,一股臭味

不仅如此!
底裆还有不一般的地方:添加聚乳酸+持有国家认证的检测报告,能更好的帮你呵护私处。

而且0印染0荧光0甲醛,保持zui健康安全的原木浆色,主打的是一个安心舒适!

我安利这款的原因还有一个:它能做到收腰+提臀的效果!
同时,真的把裸感也做到了极致,不会给你带来一丝束缚,穿上真会上瘾~
正面看👇

侧面看👇

同事经不住诱惑上身试穿,简直就是“背影杀手”,有腰又有屁股,谁看谁不迷糊呢!

而且这一次我们是有备而来!给大家争取了福利,这次的开团价:59元/四条!
卖完下次就不是这个价了,姐妹们赶紧带几条走吧~

很多人可能会认为:100%纯棉是最好的,其实不然!
纯棉的短植物纤维,特别容易飞灰、掉渣,进入阴道,就容易引起妇科疾病。

而且棉本身没有弹性,穿起来硬硬的很不舒服。所以,一般棉质内裤会添加适量的氨纶,让内裤更舒适耐穿。

我们这款,裤身原料是95%棉和5%氨纶。
采用面料中的软黄金——新疆棉。光照时长达到了15小时,结出的棉花色泽洁白,更有韧性,品质也更稳定。

同时,它拥有高弹性、高柔软性、高吸水性。用它做成的面料如云朵般亲肤的触感,对肌肤0刺激0伤害。

拿到手上那一刻触感非常柔软,我真的感觉好像摸到了婴儿的小肚子!

拿起来抖一抖,大家看得到的柔顺质地,轻盈又垂柔~

加上面料采用40s高支纯棉(市场上普遍用的是32支,高端品牌用的是40支),无论软糯度还是亲肤透气性,都是内裤中佼佼者。

你看,蒸汽能在内裤来去自如,可以快速排出汗水、热气。

让咱公司的妹纸试穿都说:“滑溜溜的质感,比硬邦邦的纯棉内裤舒服多了!”


内裤的核心就是底裆。
DANMO这款内裤底裆的主料是棉,不管是舒适性还是排湿性,棉质都是yyds的存在。

除了棉,它还加入从玉米等植物提取的天然成分——聚乳酸
//聚乳酸有“女性守护神”之称,能完美匹配女性私处的酸碱度,抗jun除异味,温和养护私处。

尤其对引起妇科问题的大肠杆菌、金色葡萄球菌、白色念珠菌抑制率非常高。

特意做了个实验给大家瞧瞧:
穿DANMO原棉内裤之前,菌落多而密集,穿上之后细菌明显变少甚至没有了。
聚乳酸还有比普通内裤高出10倍的去污力。
我们用酱油模拟分泌物/姨妈血,污渍一搓就干干净净!丝毫不费劲!

而且它穿久了不会发黄变硬,反而越洗越软!
像我这条已经穿了2个月,到现在裆部不发黄、不变硬,还和新的一样柔软干净。


很多人穿内裤动不动就卡屁股缝,尤其是春夏裤子穿得薄了,内裤卡住就特别尴尬……

自从我换上这款,再也没有这种困扰了~
✅采用3D立体剪裁设计,提臀效果非常棒,轻松塑造圆润翘臀!

9cm高腰360°微压收腹,包裹住腰腹部游离的赘肉,“大腹婆”秒变小蛮腰!

内裤加大包臀面积,严丝合缝的包裹住臀部。
不管你运动、跑步,还是剧烈运动,它都不会移位、卡屁屁,让你杜绝在公共场合“抠PP”的尴尬~

✅整体高弹不紧绷,毫无束缚感。
不用担心身材不适合,因为它具有超强的弹力,高矮胖瘦都能接纳你的身材,而且是久穿不变形。

另外,品牌方为了让它的舒适度更上一个台阶。
内裤的细节更是做到极致,裆部走线工整紧实、基本没线头:

缝合处做了加固,久穿不坏,让你不花一分冤枉钱~


当然,还有“颜值党”的执念:内裤,一定要好看!

这款奶fufu~的颜色,穿浅色/单薄的裤子裙子不会透出内裤底色,四季都能穿!

腰腹部做了暗纹提花,每款的花样都不一样
把这几款穿在身上,每天治愈好心情,你不是香香软软的小公主谁是?

尺码可以根据体重范围选择!M码-XXL码(80-160斤)胖瘦妹纸都能找到适合的。

最关键的是,这条全方面打满分的王牌内裤,还给你超乎想象的性价比!
tb上光是纯棉稍微好些的都要150+:

咱这款价格还无敌亲民!原价129元/4条,今天下单:
工厂直发,没有中间商赚差价
59元拿下4条!
平时路边摊一条也要十几块,更别说咱还是带抗jun、显瘦收腰效果的内裤!
内裤三月一换,趁活动赶紧给自己、家人安排上!
